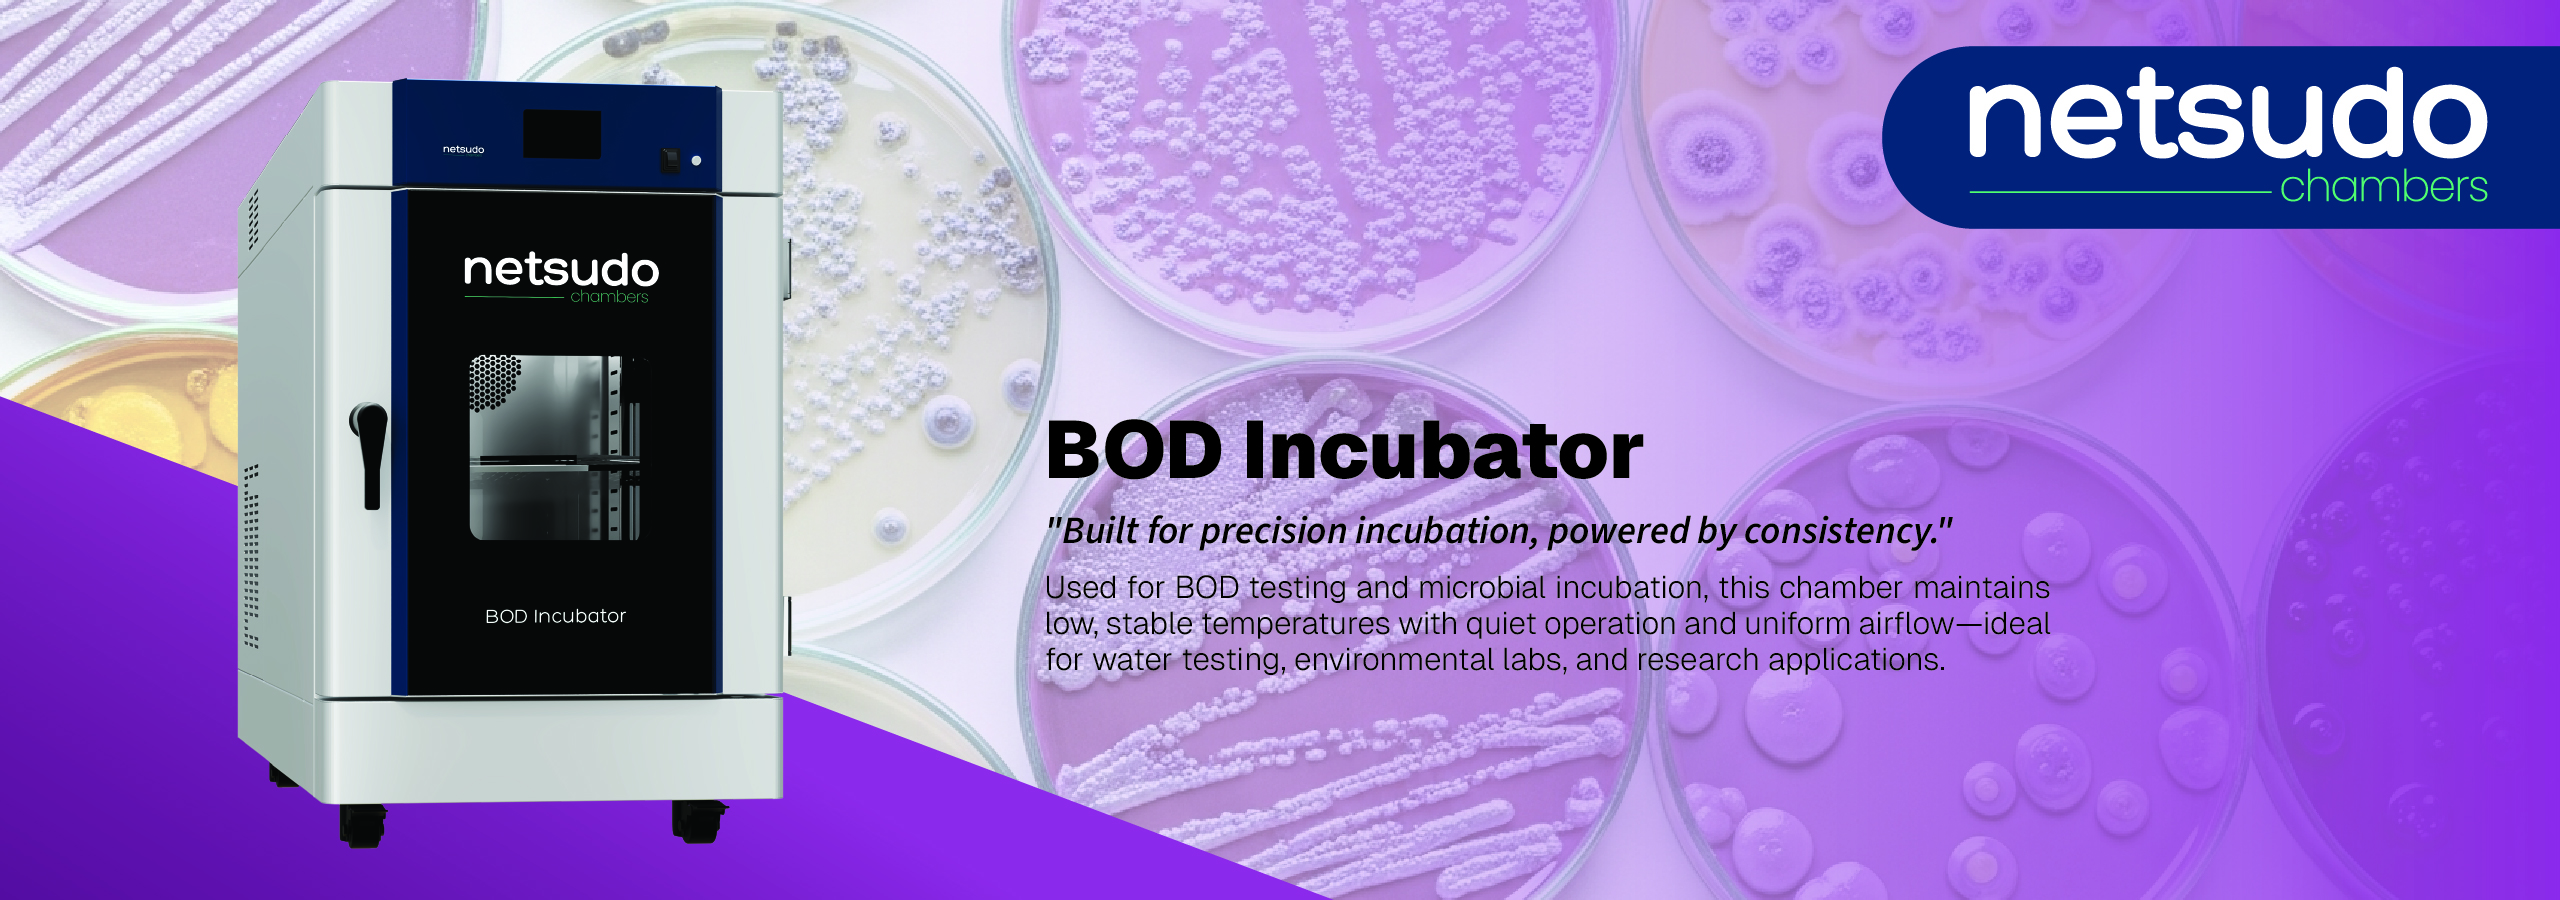
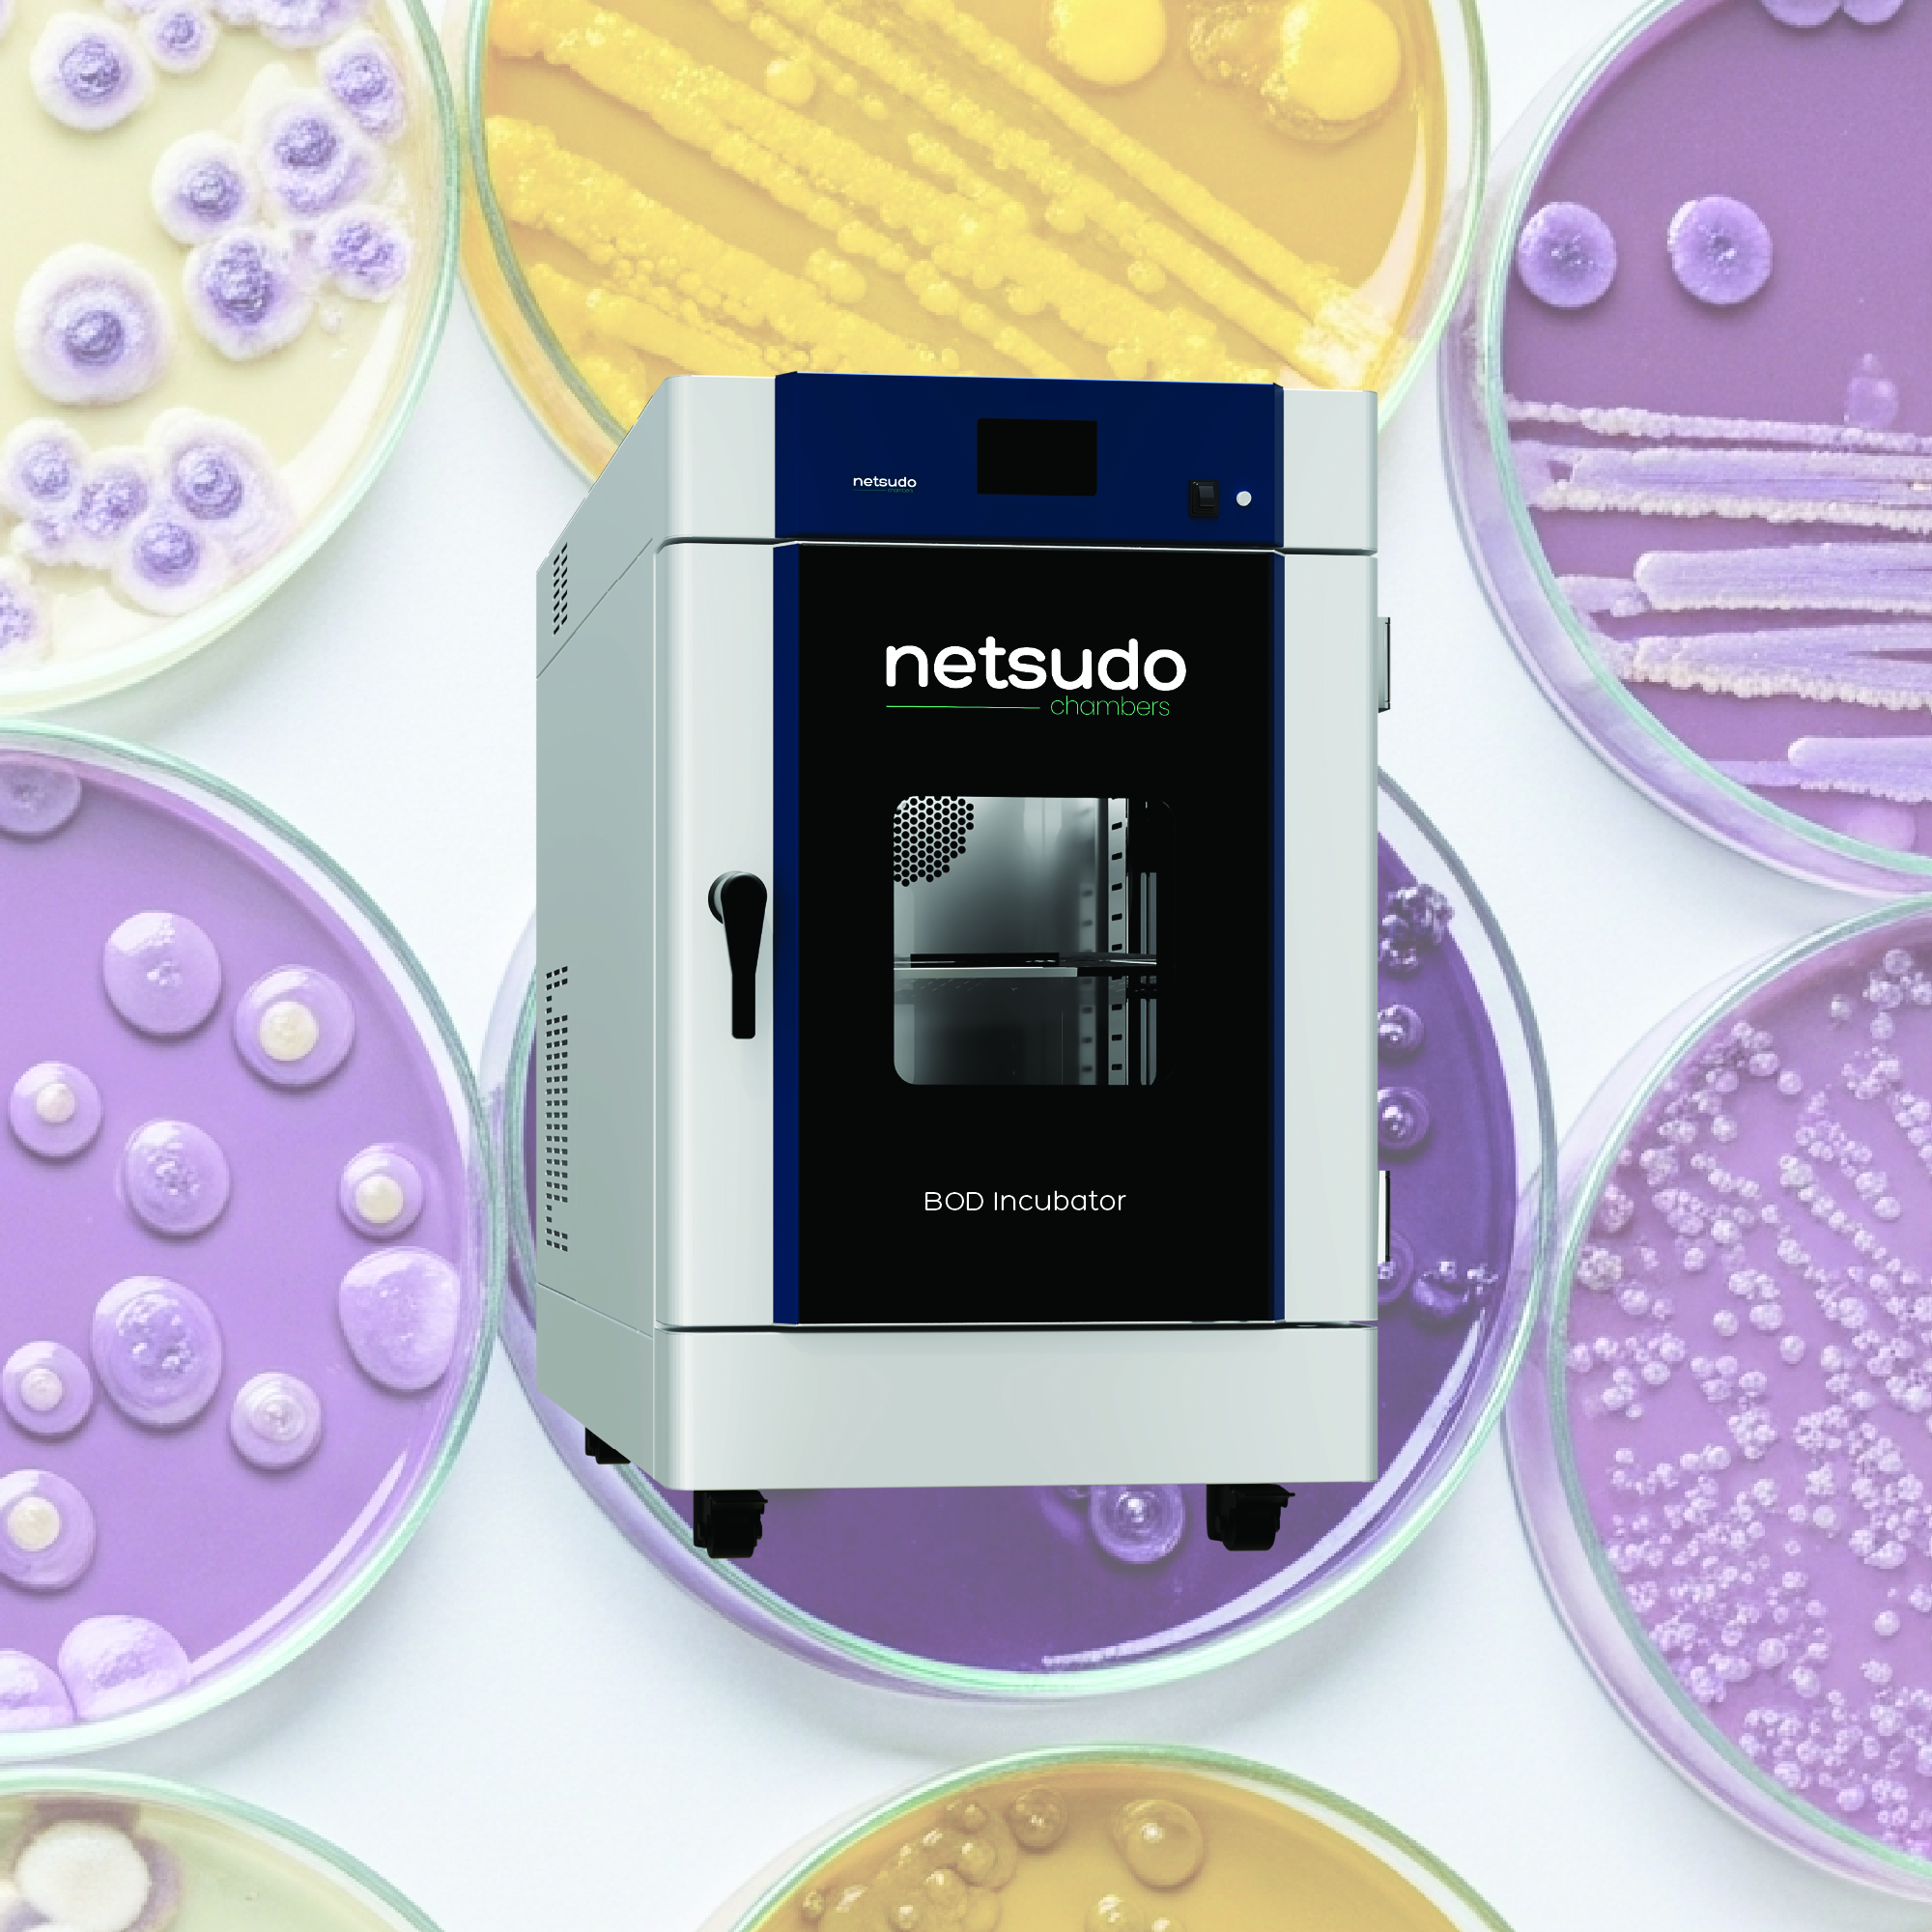
Optimized VCRS
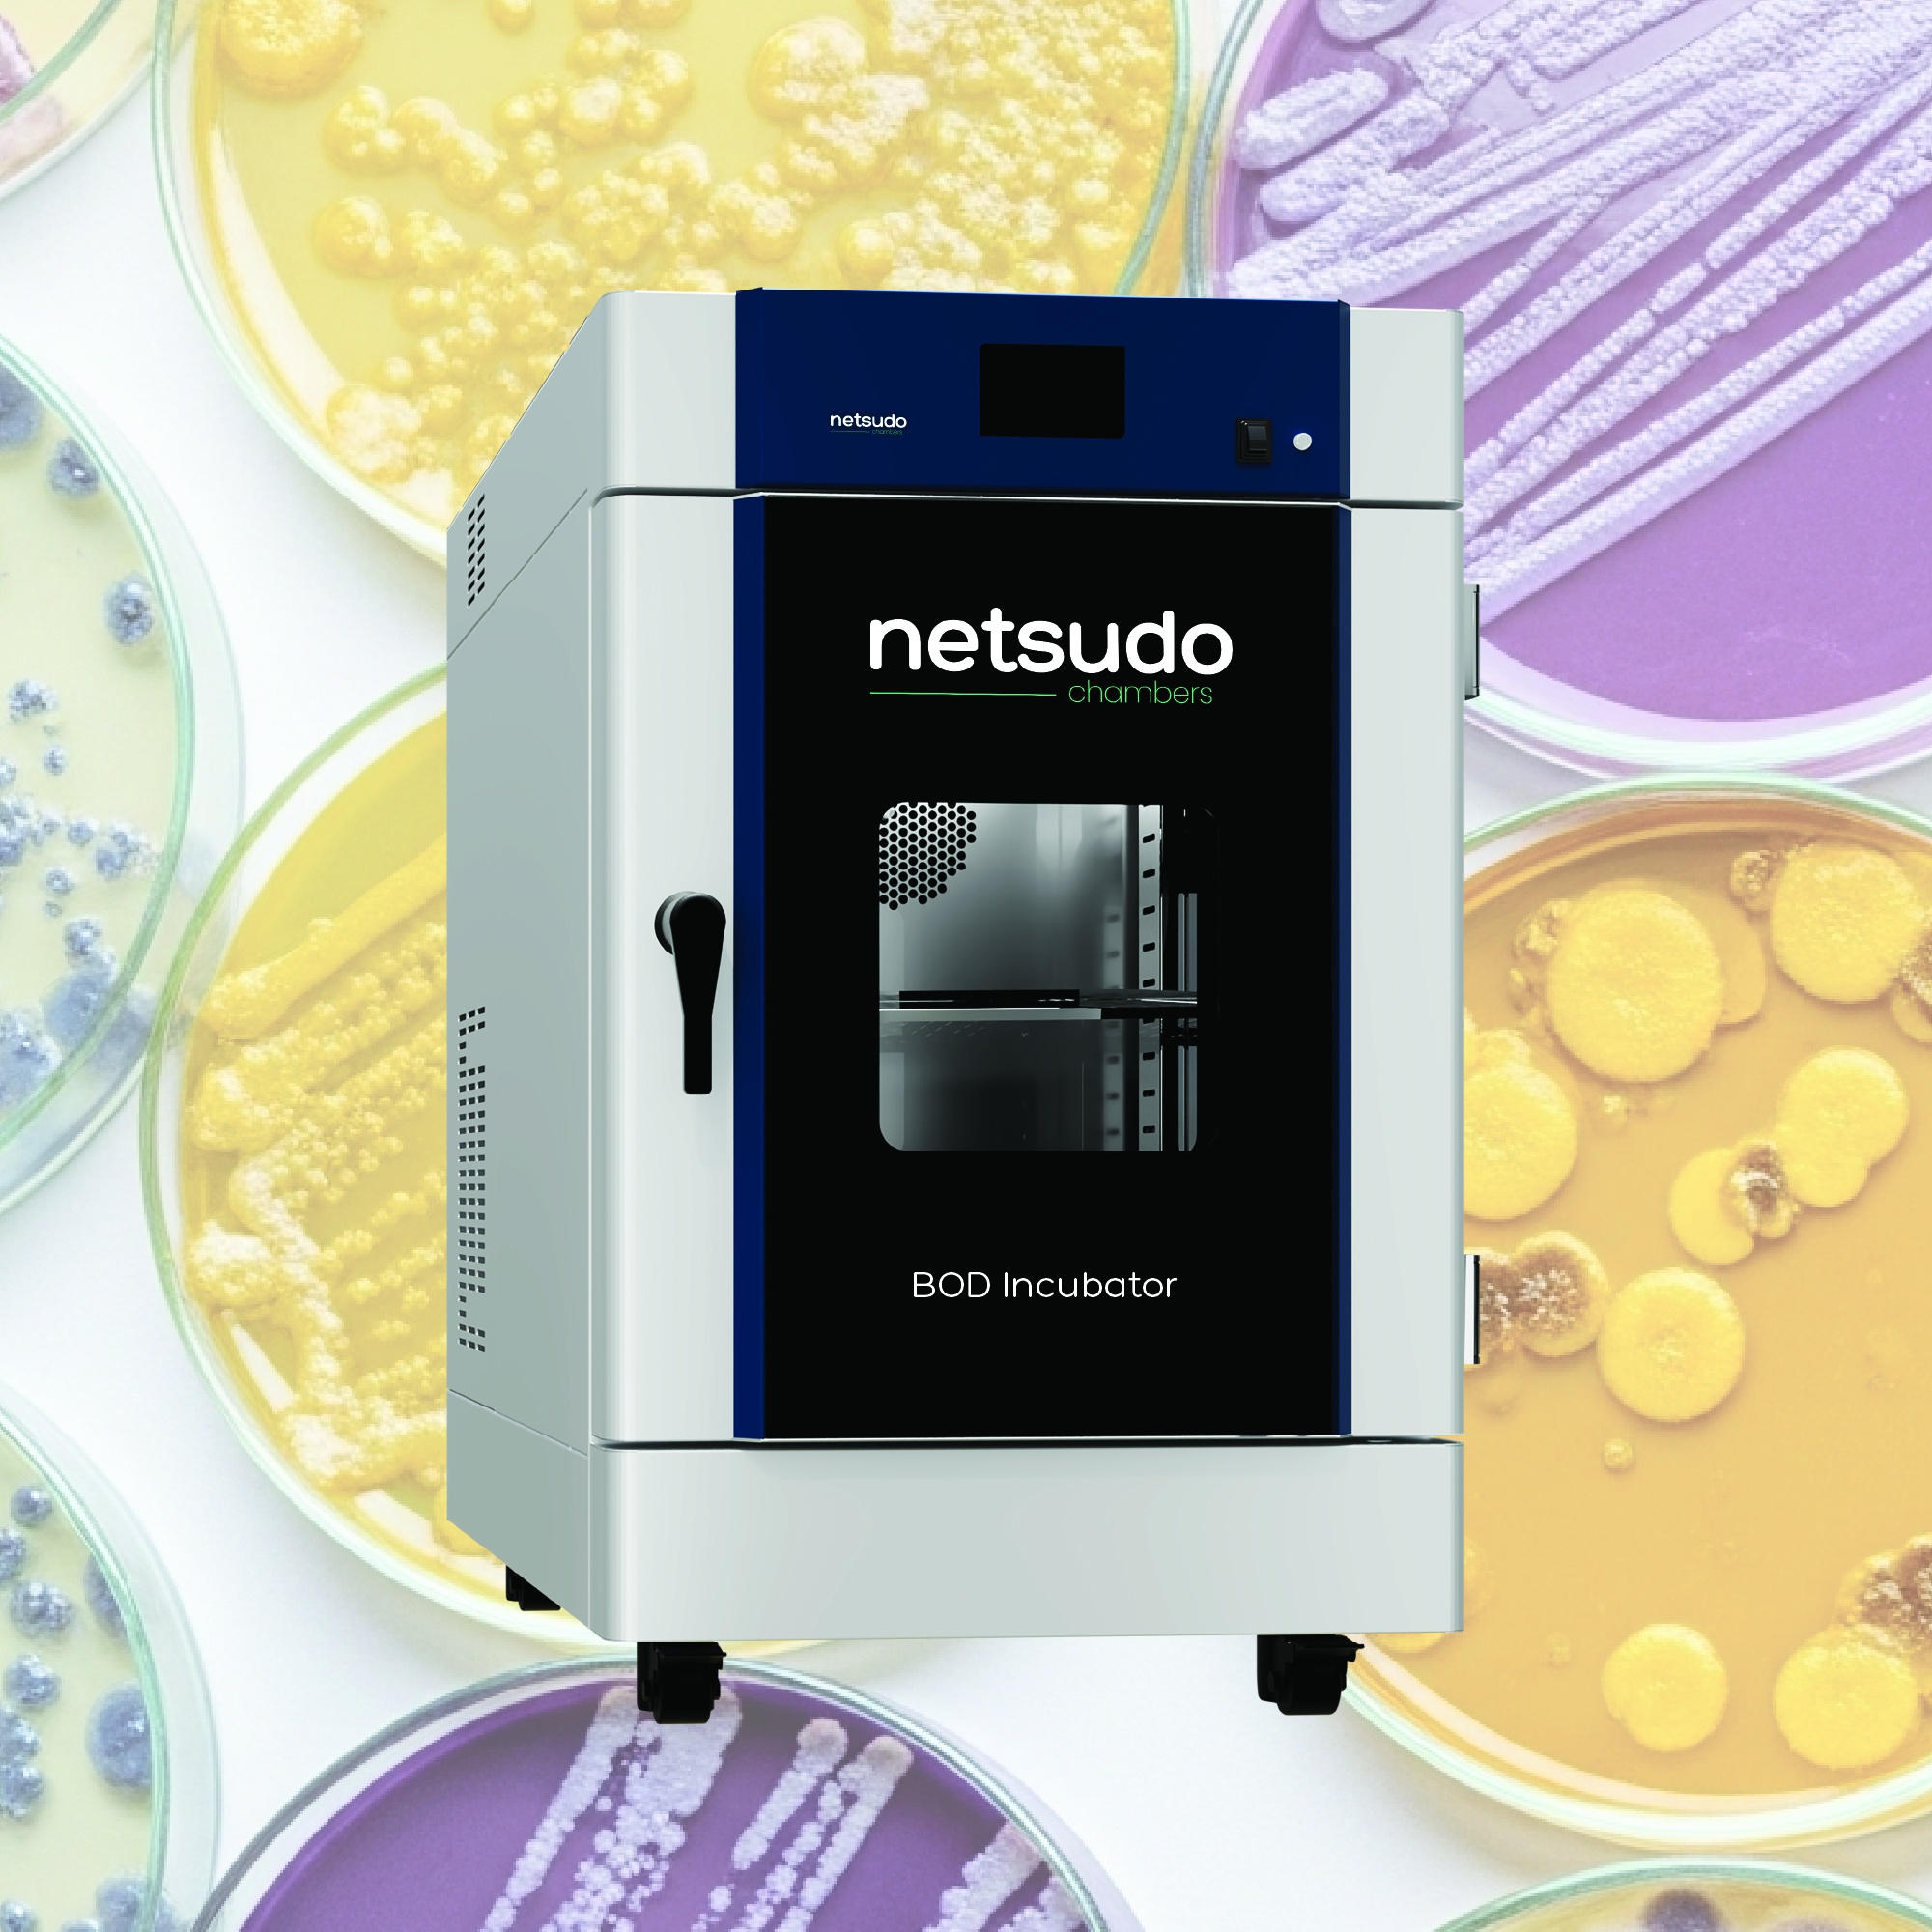
Hybrid Humidifier
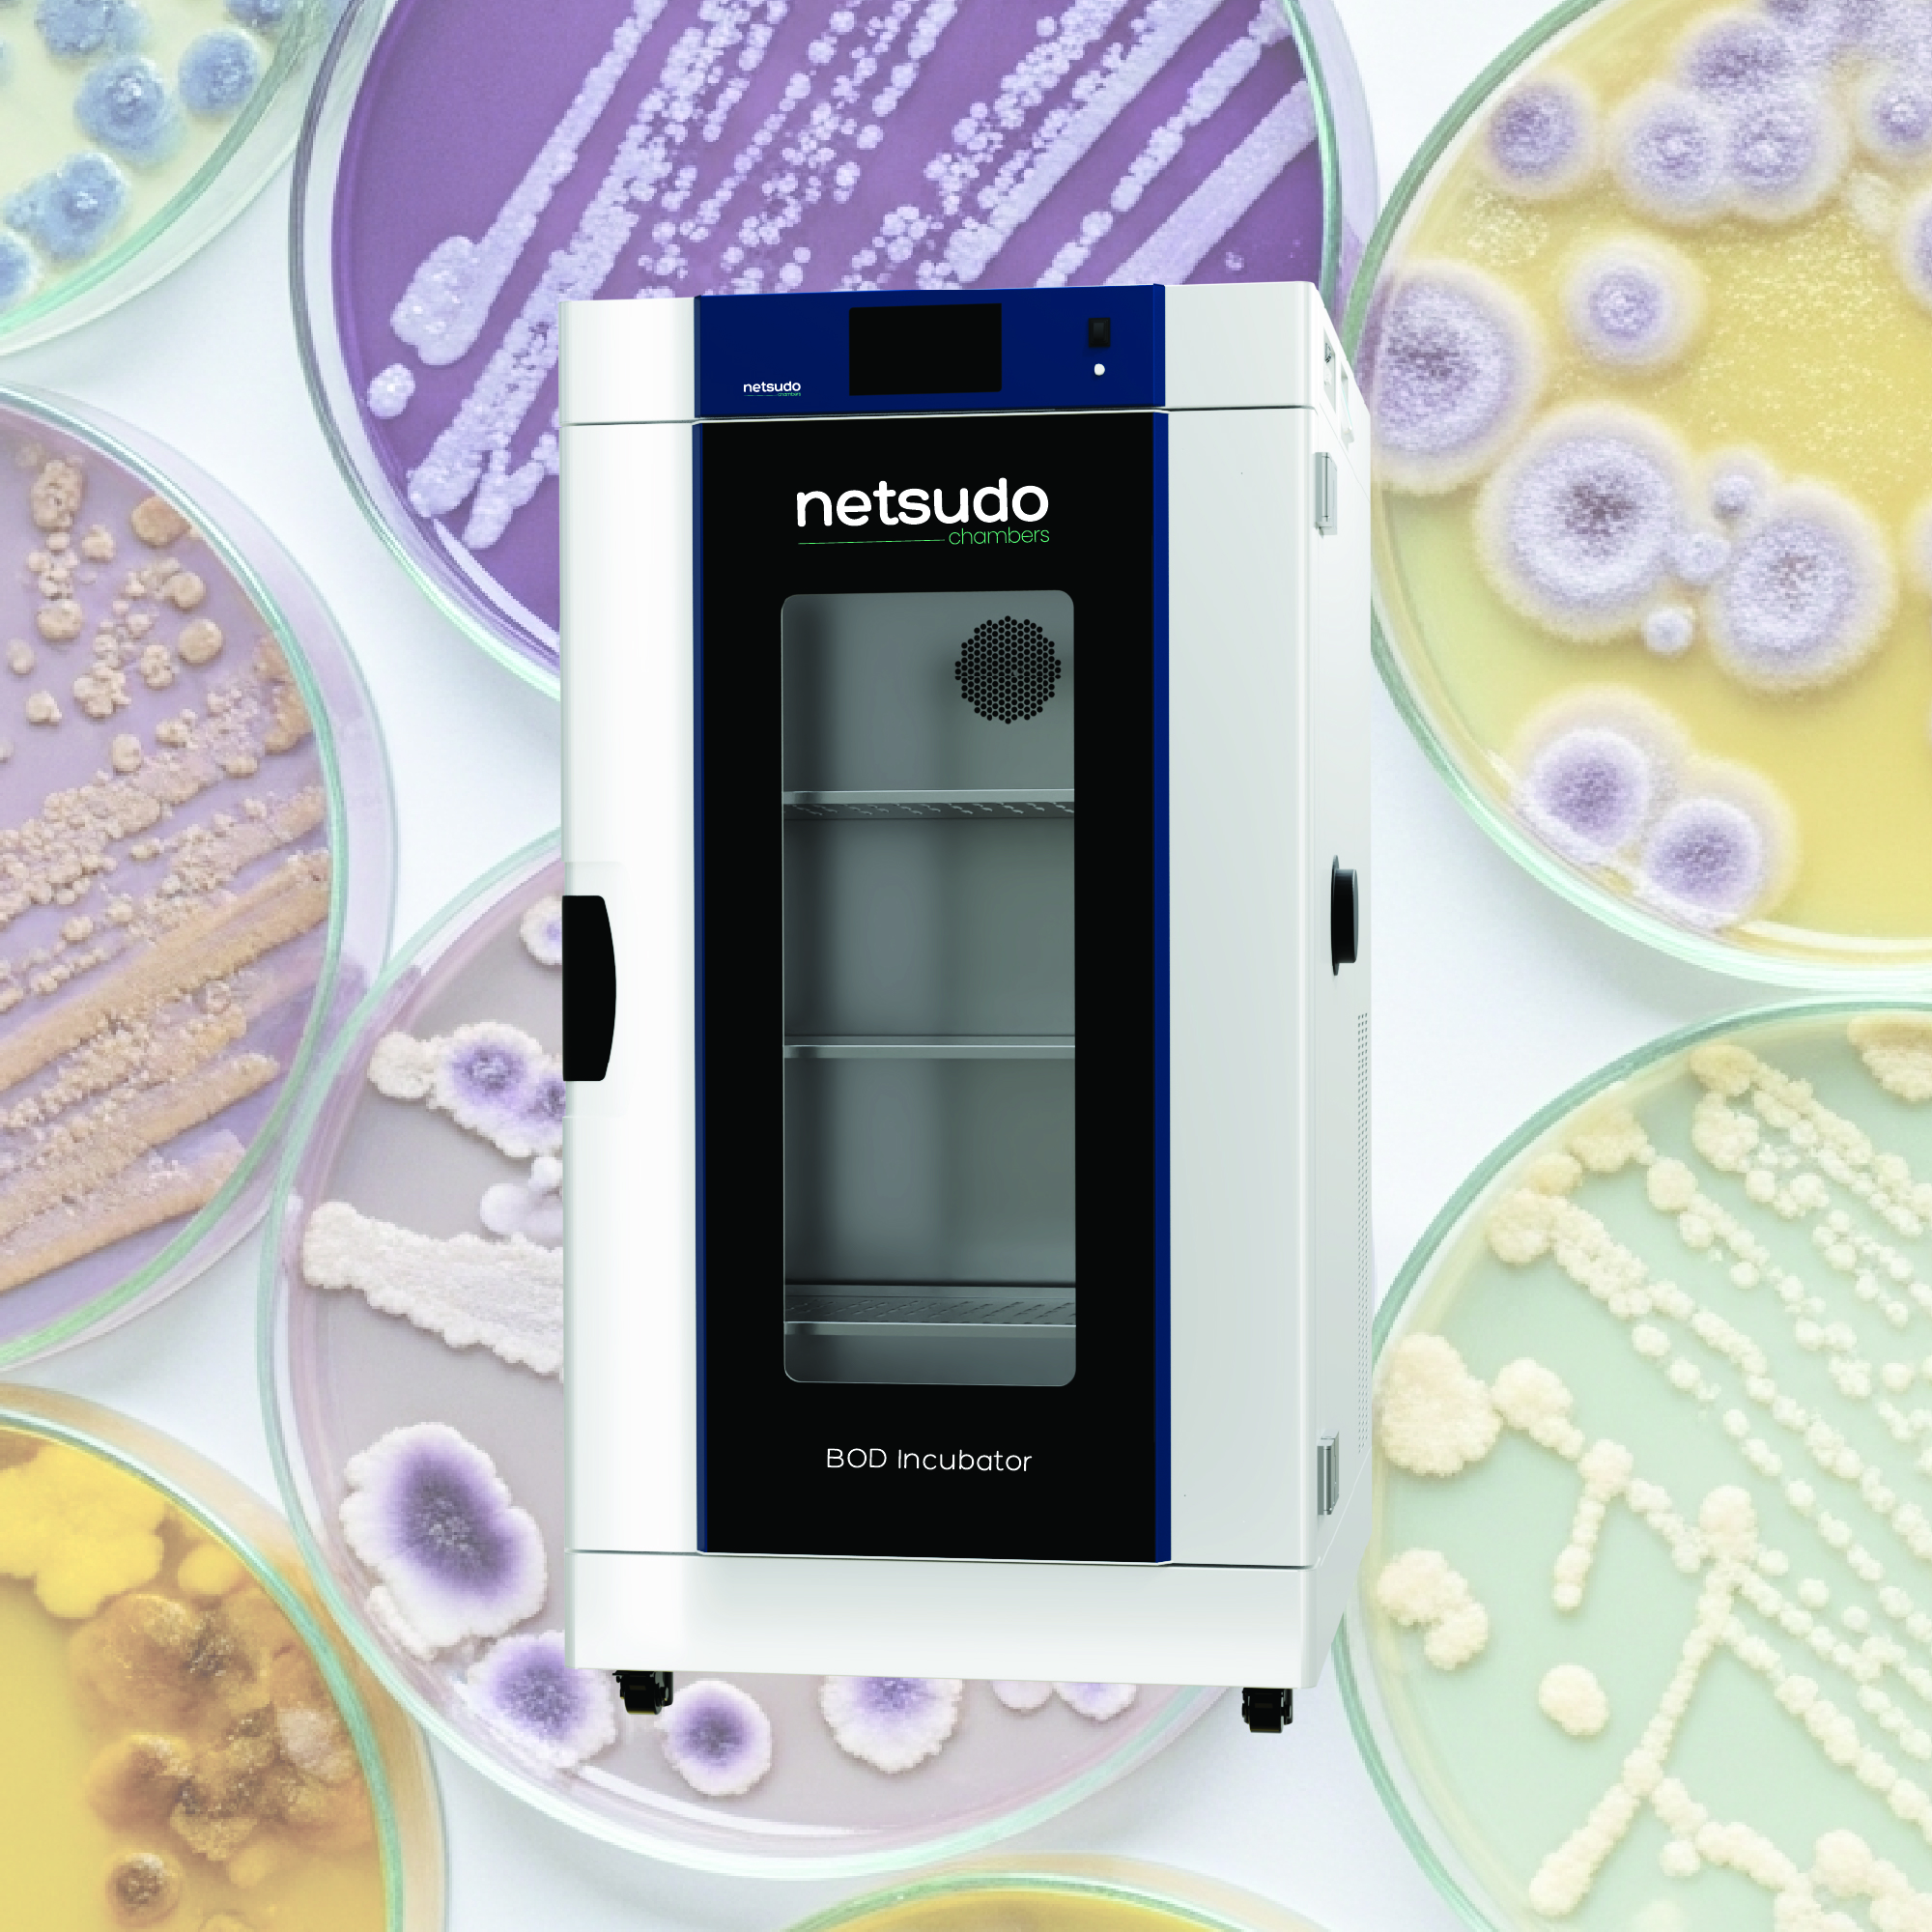
Illumination
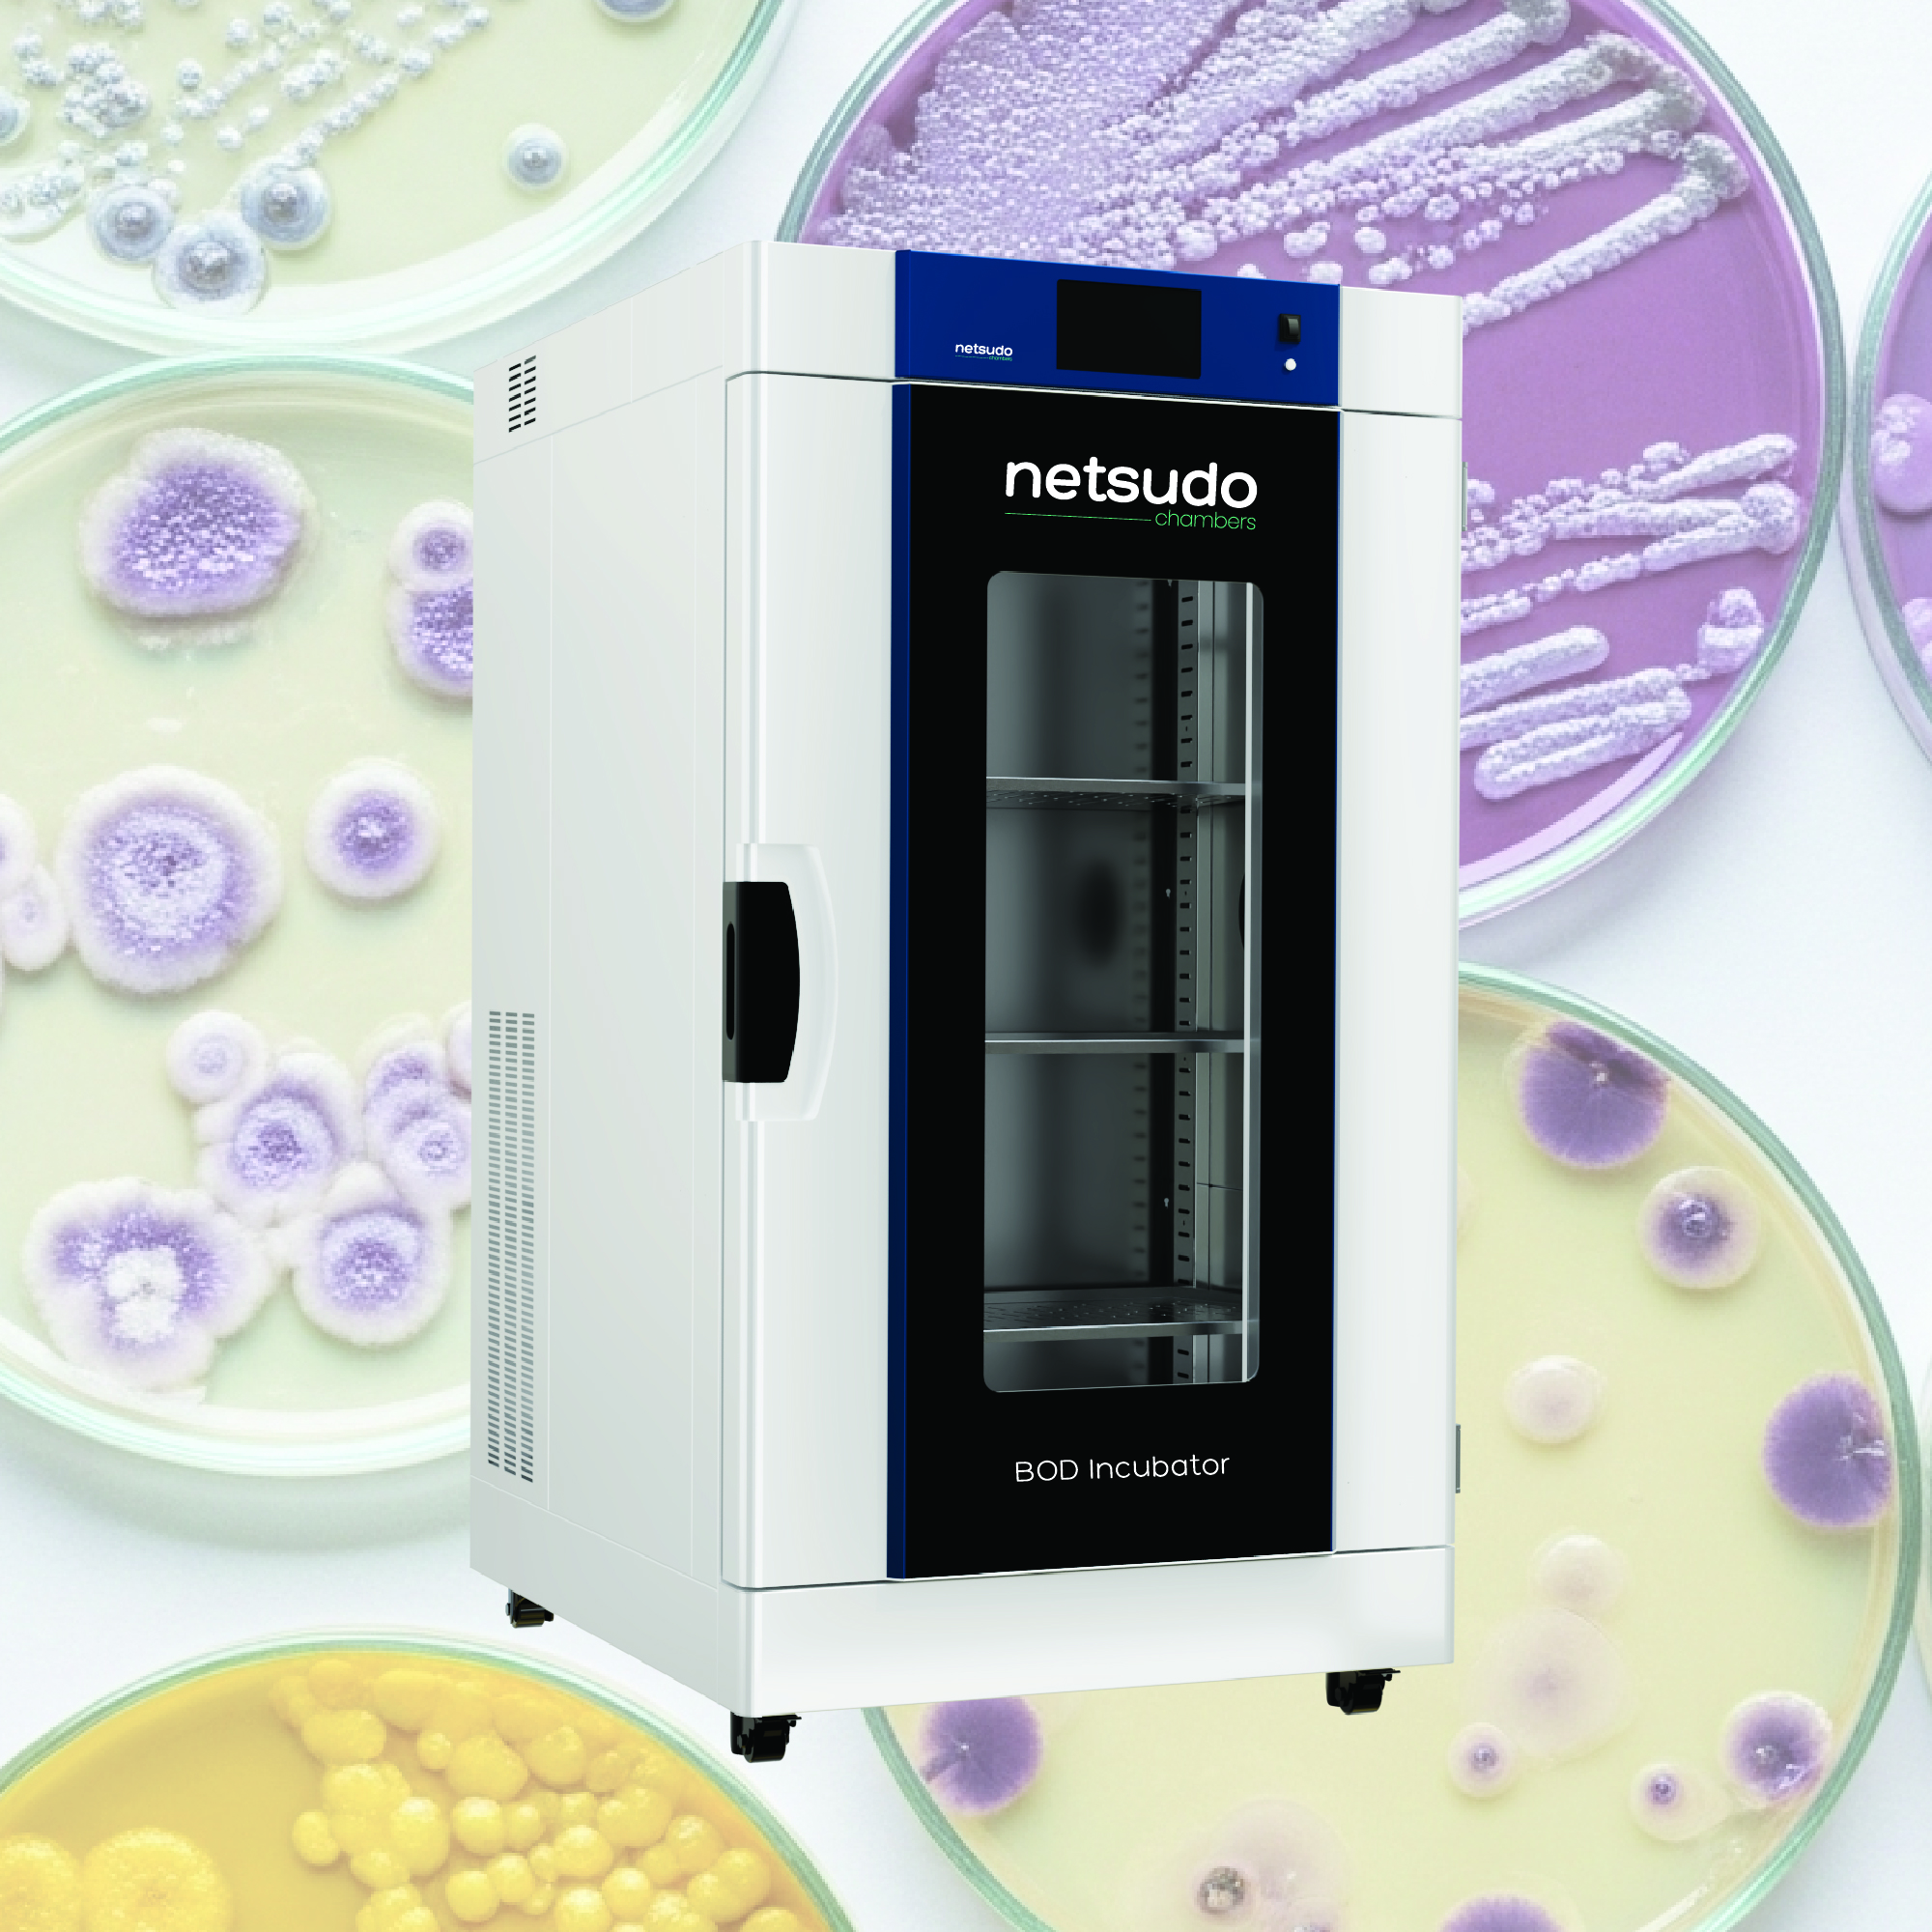
Safety
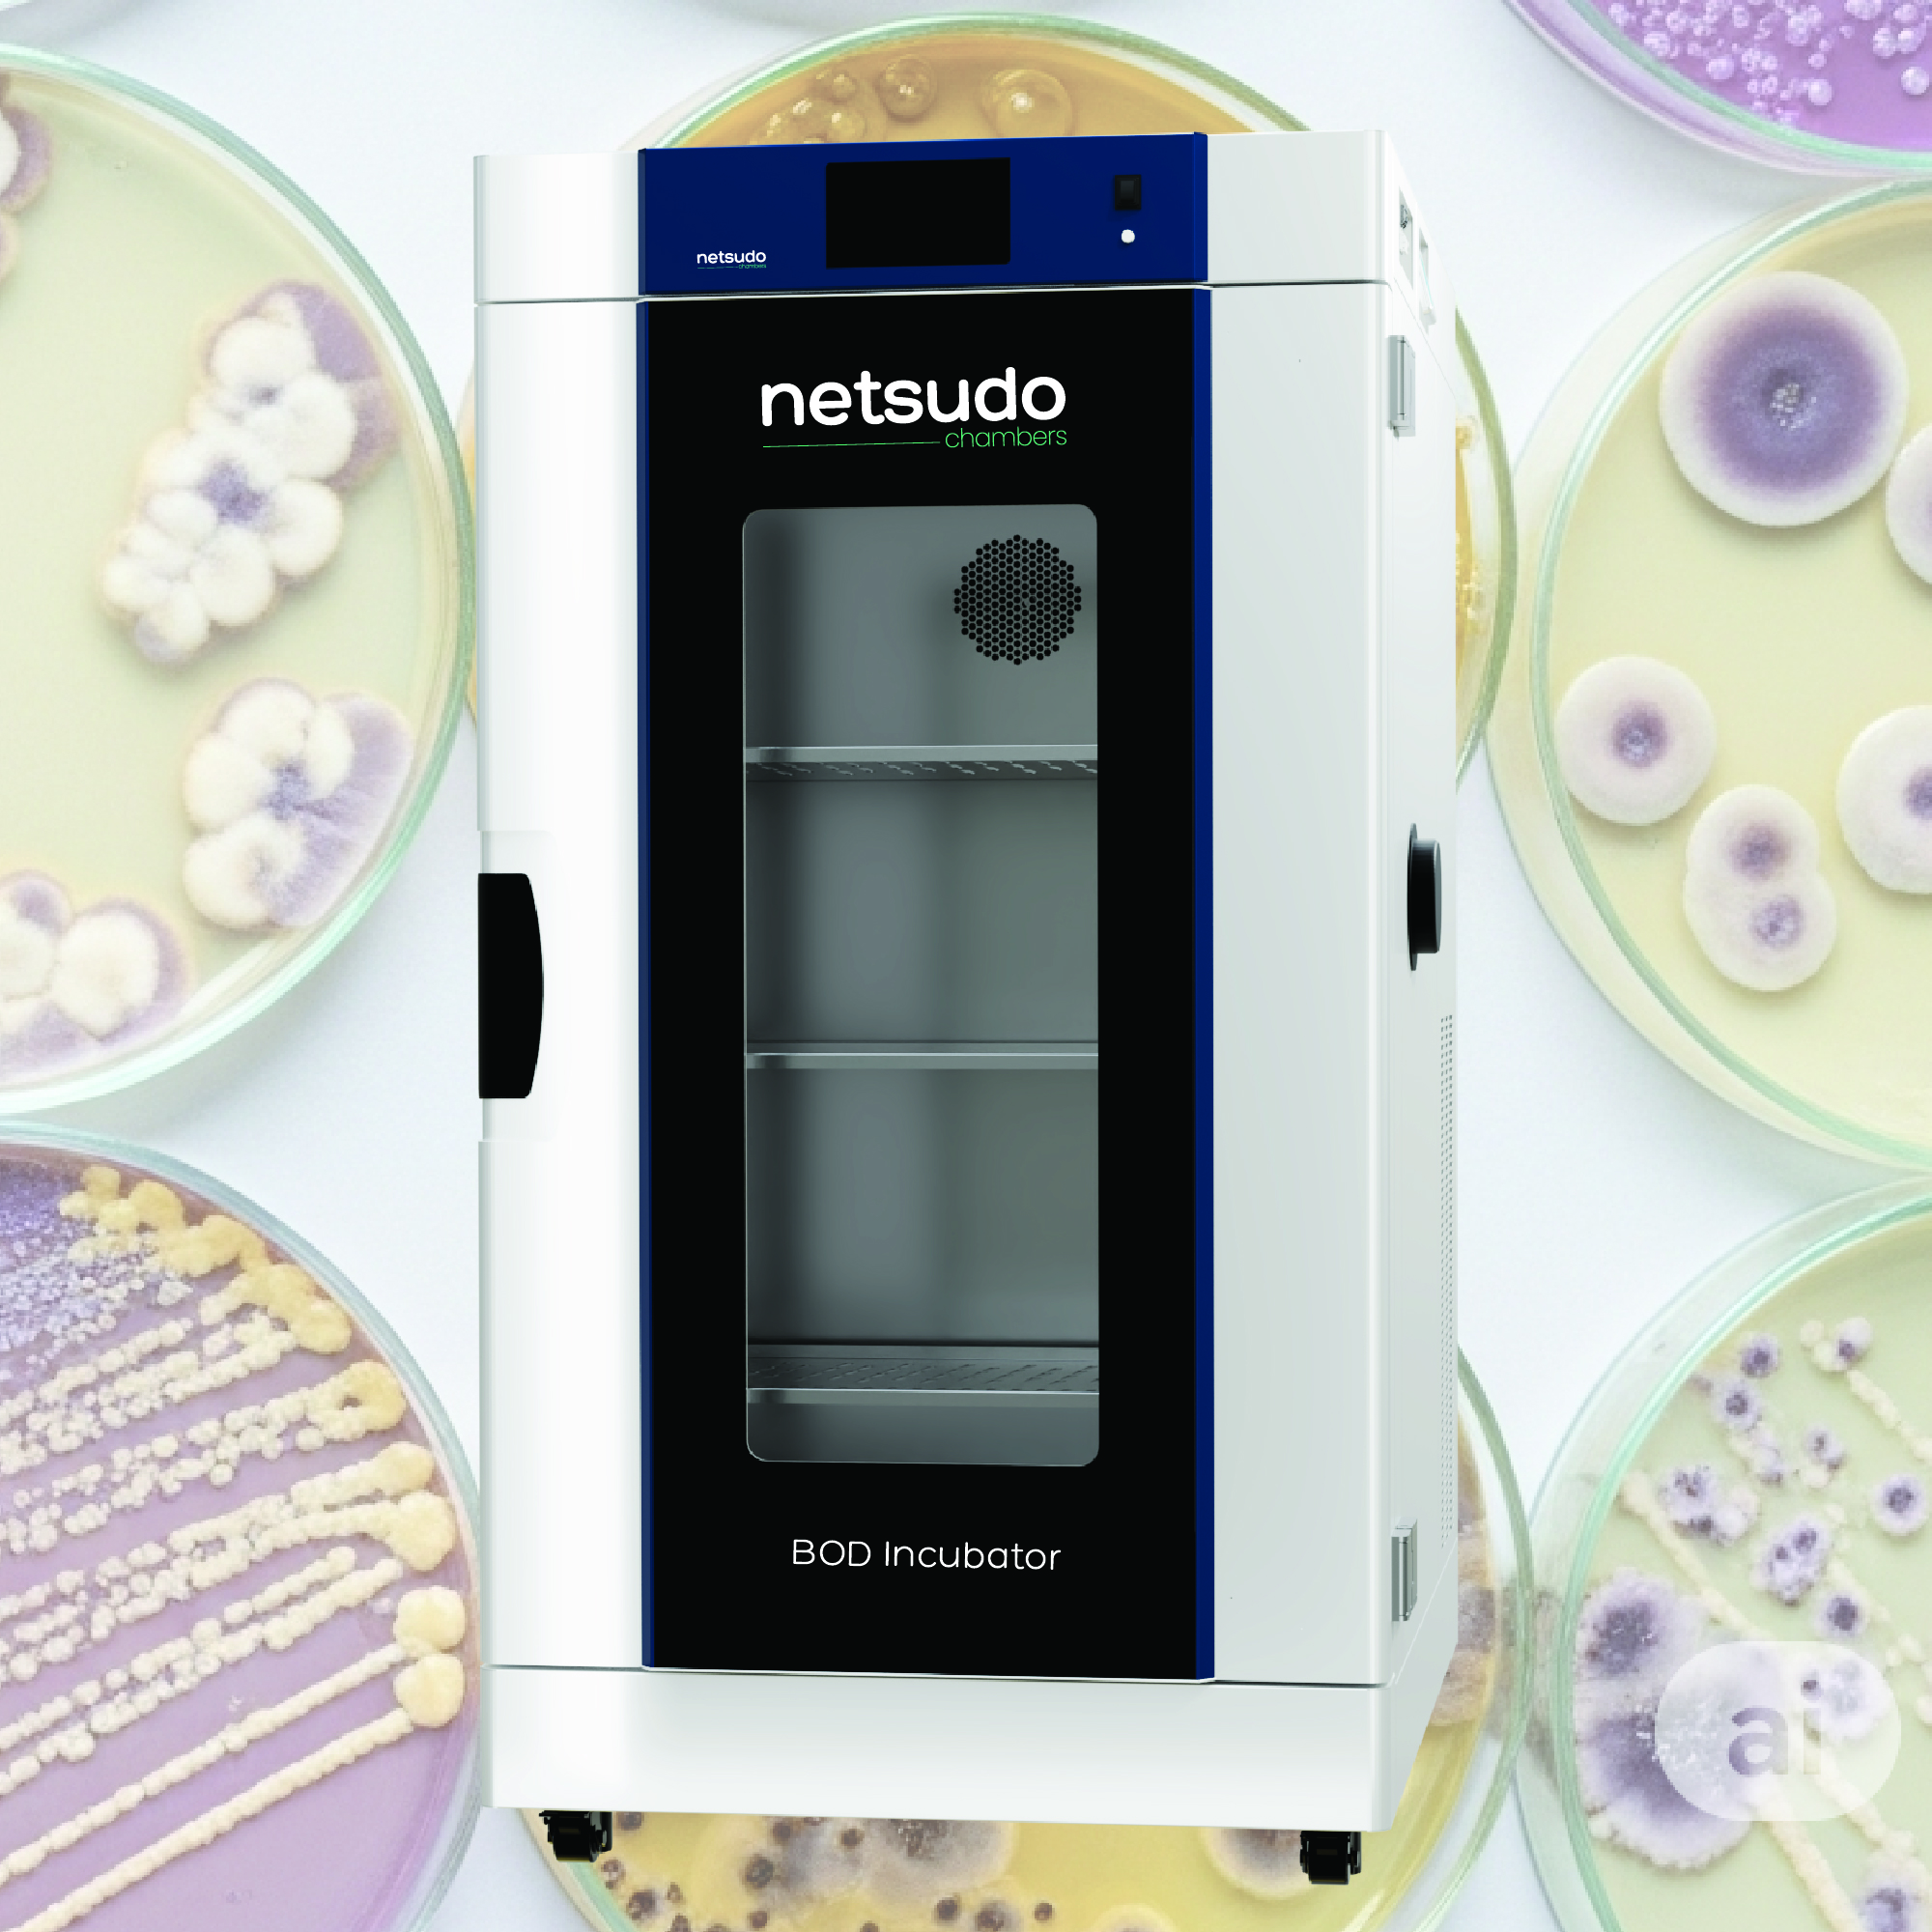
Intelligent Control

KEY FEATURES OF BOD INCUBATOR
- Designed for reliable BOD testing, microbial incubation, and environmental studies
- Precise temperature control from 5°C to 60°C with uniform distribution
- Energy-efficient cooling system ensures low operational costs
- Ideal for wastewater analysis, pharmaceutical, and research applications
- Available in multiple sizes with digital controls and programmable settings
Technical Specifications

Available Models Series - NCBDXX
NCBD9-90L
With a 90-liter internal capacity, this compact BOD incubator ensures precise temperature control for microbial growth and biochemical studies. Ideal for labs requiring reliable performance in a space-efficient design.
NCBD20-200L
Offering 200 liters of internal space, this BOD incubator provides stable temperature environments for wastewater testing and incubation needs. Suitable for research, biotech, and environmental quality control applications.
NCBD40-400L
This 400-liter BOD incubator delivers accurate temperature regulation for large sample volumes. Designed for long-term microbial incubation, it supports routine lab work in pharmaceutical and environmental industries.
NCBD75-750L
With a spacious 750-liter capacity, this BOD incubator is ideal for high-volume microbial studies. It ensures consistent cooling and temperature uniformity, making it reliable for industrial and academic applications.
NCBD100-1000L
The 1000-liter BOD incubator is engineered for large-scale testing environments. It delivers uniform temperature control, optimal for biochemical oxygen demand studies and microbial incubation in commercial and research settings.
“A well-made product doesn’t chase trends — it sets its own standard.”
— Ethan Caldwell
